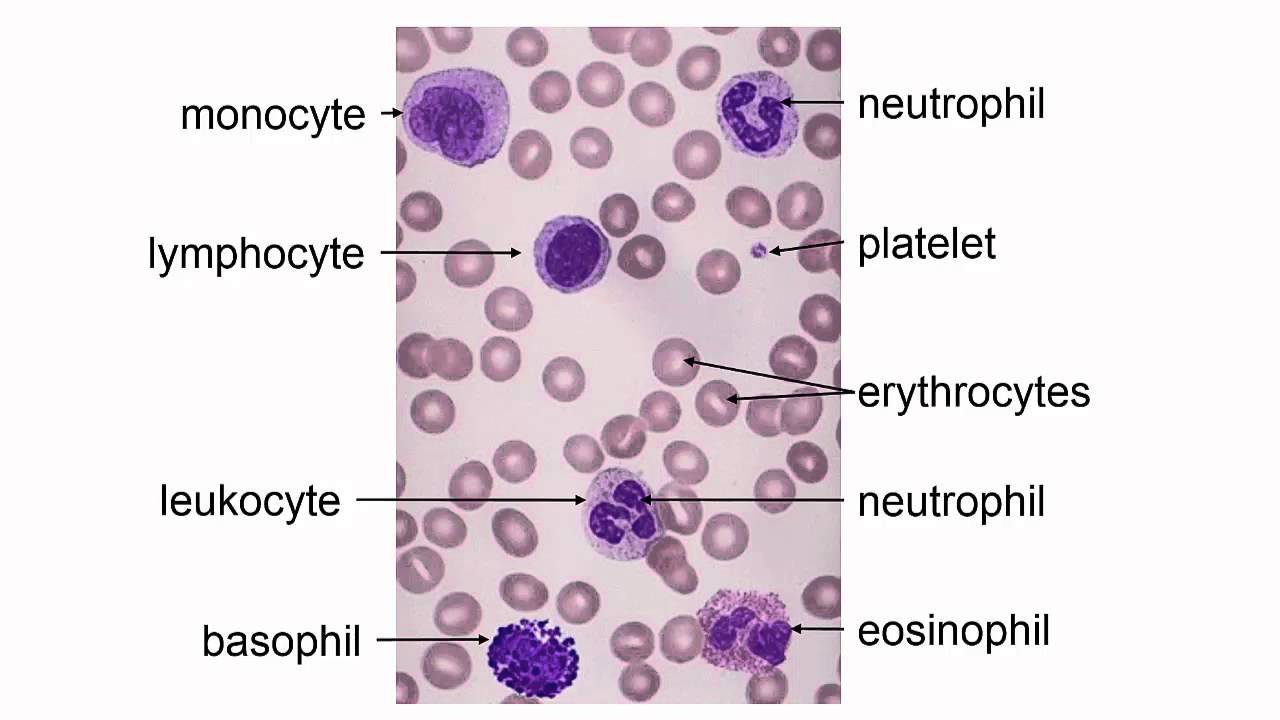

|  | Downloading from: https://www.youtube.com/channel/UCm0BIv1JbJHeZFBufMeJr2g/about | YouTube | | HS21+ US History ... |
 |  | Introduction to Polynomials | YouTube | Polynomial vocabulary: term vs factor, monomial/binomial/trinomial/polynomial, etc. | EdCC Algebra I |
 |  | How to Write Essays and Research Papers More Quickly | YouTube, "NEW" HS+ English, US History, and Art... | Check out Brilliant.org to start learning for free - and be among the first 200 people who sign up to get 20% off your subscription: https://brilli... | "Pre Converted" H... |
 |  | Stroke | YouTube | by J John Cohen, MDCM, PhD for the CU Mini Med School | Human Anatomy |
 |  | Quantitative vs. Qualitative Research: The Differences Explained | Scribbr 🎓 | YouTube, "Pre Converted" HS+ English and Life S... | There are two approaches to collecting and analyzing data: qualitative research and quantitative research. This video will explain the differences ... | "Pre Converted" H... |
 |  | Mitosis 4- Cell cycle | YouTube | Part 4 in an 8 part lecture on MITOSIS in a flipped General Biology course taught by Wendy Riggs. CC-BY. Watch the whole lecture (all 8 videos) by ... | HS21+ Life Scienc... |
 |  | Block Letter Format Google Docs | YouTube | | HS21+ Life Scienc... |
 |  | Parts of a Paragraph | I-DEA, Summer | | |
 |  | Time Management | YouTube | This video will guide you through the process of managing your day and helping you make use of wasted time by beating procrastination.
For more inf... | Health-VideoConve... |
 |  | Mitosis 3- Chromosomes | YouTube | Part 3 in an 8 part lecture on MITOSIS in a flipped General Biology course taught by Wendy Riggs. CC-BY. Watch the whole lecture (all 8 videos) by ... | HS21+ Life Scienc... |
 | | Hematopoetic 1 | YouTube | by J John Cohen, MDCM, PhD for the CU Mini Medical School | Human Anatomy |
 |  | Leyla Acaroglu- Paper Beats Plastic (How to Rethink Environmental Folklore) | HS21+, Contemporary World Problems, Module 02, ... | Contemporary World Problems - Module 02 | HS21+ |
 |  | How to Create a PowerPoint Presentation | YouTube | This is a tutorial for elementary students to create a PowerPoint presenation | Portfolio |
 |  | PowerPoint 2007 Demo: Create a basic presentation quickly | YouTube | See more PowerPoint 2007 demos at http://office.microsoft.com/en-us/hel... If you're new to Microsoft Office PowerPoint 2007 and just want to pick ... | I-DEA Spring - Of... |
 |  | We are still here - with subtitles | YouTube, "NEW" HS+ English and Contemporary Wor... | | "Pre Converted" H... |